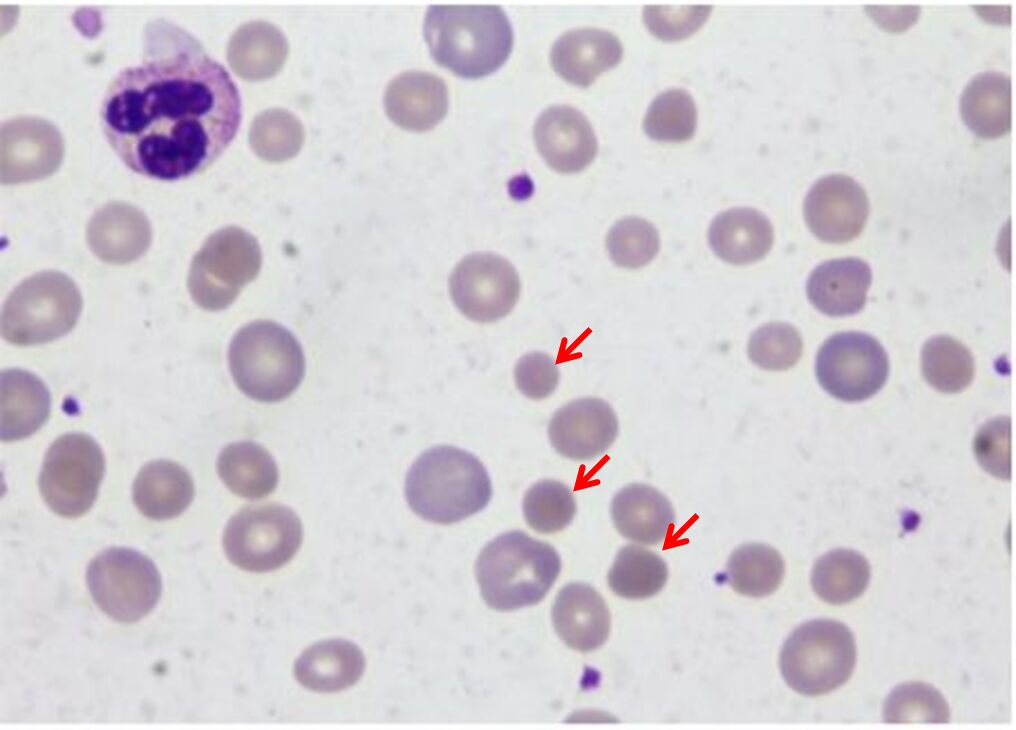
68596368a3e23.jpg

1. 一位23歲男性過去無特殊不適,在當兵前體檢發現輕微貧血及黃疸,Hb 11.1 gm/dL, WBC 5990/uL,platelet 172000/uL,bilirubin全量4.1 mg/dL,直接型0.61 mg/dL,周邊血液抹片如圖所示。此位病人最可能的診斷為何?
(A) Thalassemia
(B) Hereditary spherocytosis
(C) G6PD deficiency
(D) Chronic hepatitis
(E) Gilbert's disease
答案:登入後查看
統計: A(12), B(14), C(1), D(0), E(0) #2013800
統計: A(12), B(14), C(1), D(0), E(0) #2013800
詳解 (共 2 筆)
#4216969
thalassemia 的抹片會有target cell!
0
0
#6501525
遺傳性球形紅血球增多症(Hereditary spherocytosis)病患會有球形紅血球(Spherocyte,圖中紅色箭頭),比正常紅血球小,且沒有central pallor(中央凹陷蒼白區)。
0
0